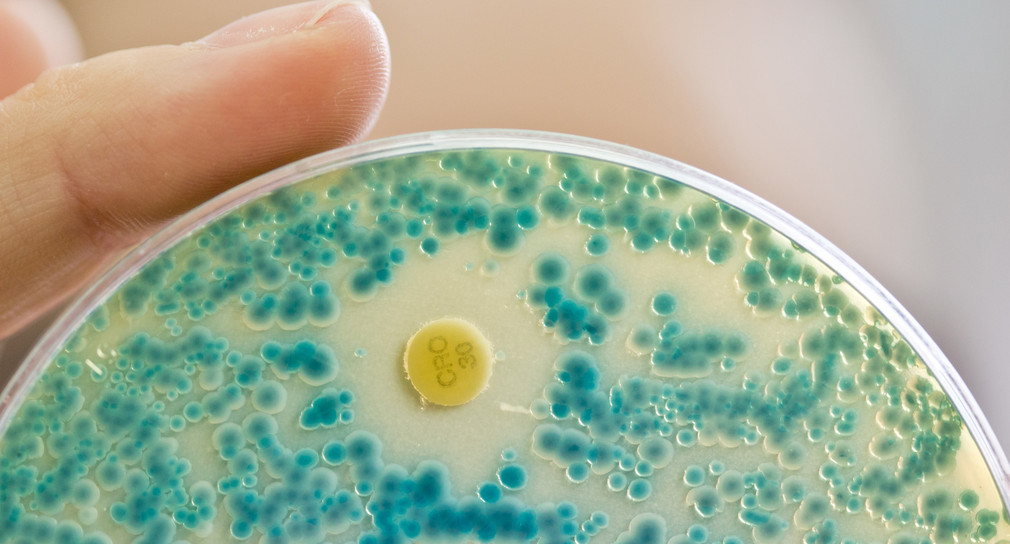

Das Wirtschaftsministerium unterstützt das Naturwissenschaftliche und Medizinische Institut der Universität Tübingen in Reutlingen mit rund 200.000 Euro. Durch die Förderung kann die Geräteinfrastruktur im Bereich der Material- und Immunologie-Forschung beschafft werden.
Das Ministerium für Wirtschaft, Arbeit und Wohnungsbau unterstützt das Naturwissenschaftliche und Medizinische Institut (NMI) der Universität Tübingen in Reutlingen mit rund 200.000 Euro für die Beschaffung von Geräteinfrastruktur im Bereich der Material- und Immunologie-Forschung. „Mit der Anschaffung dieser Geräteinfrastruktur stärken wir das Leistungsspektrum des NMI in maßgeblichen Zukunftsfeldern der Material- und Oberflächenforschung für medizinische Anwendungen, in denen erhebliches Potenzial für den Transfer von Innovationen an baden-württembergische Unternehmen steckt“, begründete Ministerin Nicole Hoffmeister-Kraut die Förderzusage.
Unverzichtbarer Partner für den Mittelstand
„Die wirtschaftsnahe Forschung außerhalb der Universitäten trägt erheblich zur Stärkung der Innovationskraft und Wettbewerbsfähigkeit unserer Unternehmen im Land bei. Die Sicherstellung der Leistungsfähigkeit dieser Forschungseinrichtungen ist wesentliche Voraussetzung für einen erfolgreichen Technologietransfer in Baden-Württemberg“, sagte Hoffmeister-Kraut. „Mit seinem Forschungs- und Dienstleistungsangebot ist das NMI ein unverzichtbarer Partner vor allem für kleine und mittlere Unternehmen (KMU), die aufgrund des hohen Kostendrucks keine eigenen Forschungskapazitäten vorhalten können, aber dennoch ständig neuen Anforderungen gerecht werden müssen.“
Mit der Förderung plant das NMI die Erweiterung der Geräteausstattung im Bereich des Forschungscampus BioMedTech. Ziel ist die Ausweitung des Forschungsspektrums zur Intensivierung der Forschungsarbeiten im Bereich der Grenzflächenimmunologie. Unter anderem soll untersucht werden, welche Materialeigenschaften künstlicher Implantate von Patienten besser vertragen werden. Außerdem ist eine Gerätebeschaffung zur Einführung eines neuartigen Beschichtungsverfahrens für Implantate vorgesehen.
Bereits im August dieses Jahres hatte das Ministerium für Wirtschaft, Arbeit und Wohnungsbau das NMI mit 700.000 Euro gefördert. Die Förderung wurde für den Aufbau einer Arbeitsgruppe für den Bereich der Biomaterialentwicklung und -verarbeitung verwendet.
Weitere Informationen
Das NMI ist eines der 13 wirtschaftsnahen Forschungsinstitute der Innovationsallianz Baden-Württemberg (InnBW). Damit die Institute ihre Aufgabe des schnellen und effektiven Technologietransfers auch künftig erfolgreich erfüllen können, müssen sie für die Wirtschaft relevante Technologietrends rechtzeitig erkennen, neue Technologiefelder erschließen und sie zum Transfer aufbereiten. Die Finanzierung dieser stark risikobehafteten Vorlaufforschung muss in erster Linie über öffentliche Forschungsgelder – vor allem über die jährlich gewährte institutionelle Förderung des Landes – erfolgen.
Das Institut betreibt angewandte Forschung an der Schnittstelle zwischen Bio- und Materialwissenschaften und konzentriert sich dabei auf die Entwicklung marktfähiger Produkte und Verfahren in den Bereichen Pharma und Biotechnologie, Biomedizintechnik sowie Oberflächen- und Grenzflächentechnologie.
Das NMI unterstützt mit seinen Innovationen aber nicht nur Unternehmen beim Erhalt von Arbeitsplätzen, es fungiert auch als Keimzelle für neue High-Tech-Arbeitsplätze. So sind allein aus bzw. zusammen mit dem NMI zwölf neue Unternehmen gegründet worden, die sich in der Nachbarschaft (Technologiepark) niedergelassen haben. Hieraus sind bereits über 200 neue Arbeitsplätze entstanden.
Wirtschaftsministerium: Innovationsallianz Baden-Württemberg